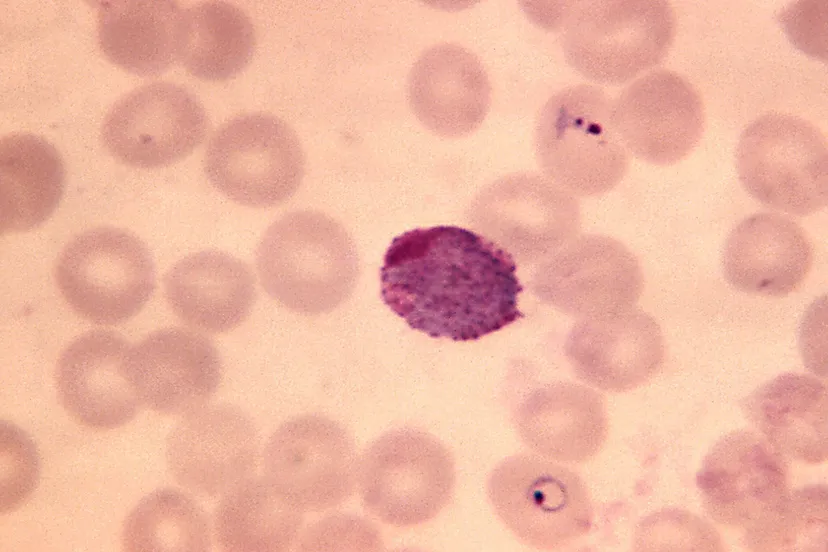
baarmoederhalsuitstrijkje

Sittardse stadsprins Thierry I verzorgt aftrap bij Fortuna Sittard
20 jan 2020, 11:11 • Nieuws

© Ton Dirkx
Op 18 januari jongstleden is Thierry Dirkx geïnstalleerd als 89e stadsprins van Sittard. Vanaf dat moment startte een periode waarin hij weinig rust zal krijgen.
De meest uiteenlopende taken, samenhangend met zijn functie, heeft Thierry inmiddels in zijn agenda geschreven. Want wat velen niet weten is dat De Marotte met prins en gevolg zeer veel bezoekjes brengen aan verenigingen, (basis)scholen, zieken, ouderen, bejaarden, muziekgezelschappen, koren en meer. Dat maakt vastelaovend in Zitterd uniek en waardevol. Dikwijls zijn het kleine bezoekjes die mensen veel vreugde brengt of zelfs even veel ellende doet vergeten. Heel waardevol en dankbaar voor een Marotteprins.
Gelukkig is er bekervoetbal!
Eén van de afspraken die de Marotteprins genoteerd heeft, is de voetbalwedstrijd Fortuna Sittard contra Feyenoord op dinsdagavond 21 januari. De eerlijkheid gebiedt echter te zeggen dat deze wedstrijd al vermeld stond in zijn agenda. Stadsprins Thierry is namelijk al vele jaren vaste supporter met seizoenkaart van Fortuna Sittard. Even dacht hij dat hij in zijn seizoen geen aftrap kon verrichten.
Tegen Vitesse was hij nog niet geïnstalleerd en tijdens de overige wedstrijden stonden andere verplichtingen gepland. Gelukkig hielpen de spelers een handje door zich te kwalificeren voor de achtste finale van de KNVB-beker. En dus heeft de stadsprins de eer op de middenstip en in het licht van de metershoge lichtmasten van het Fortuna stadion de aftrap van deze bekerwedstrijd te verrichten. Voor Thierry uiteraard een niet alledaagse taak. Menig supporter op de tribune zal waarschijnlijk jaloers zijn. Ook hij hoopt ooit eens stadsprins te worden. Of zou in elk geval de aftrap wel eens willen nemen!
Loading articles...
Loading